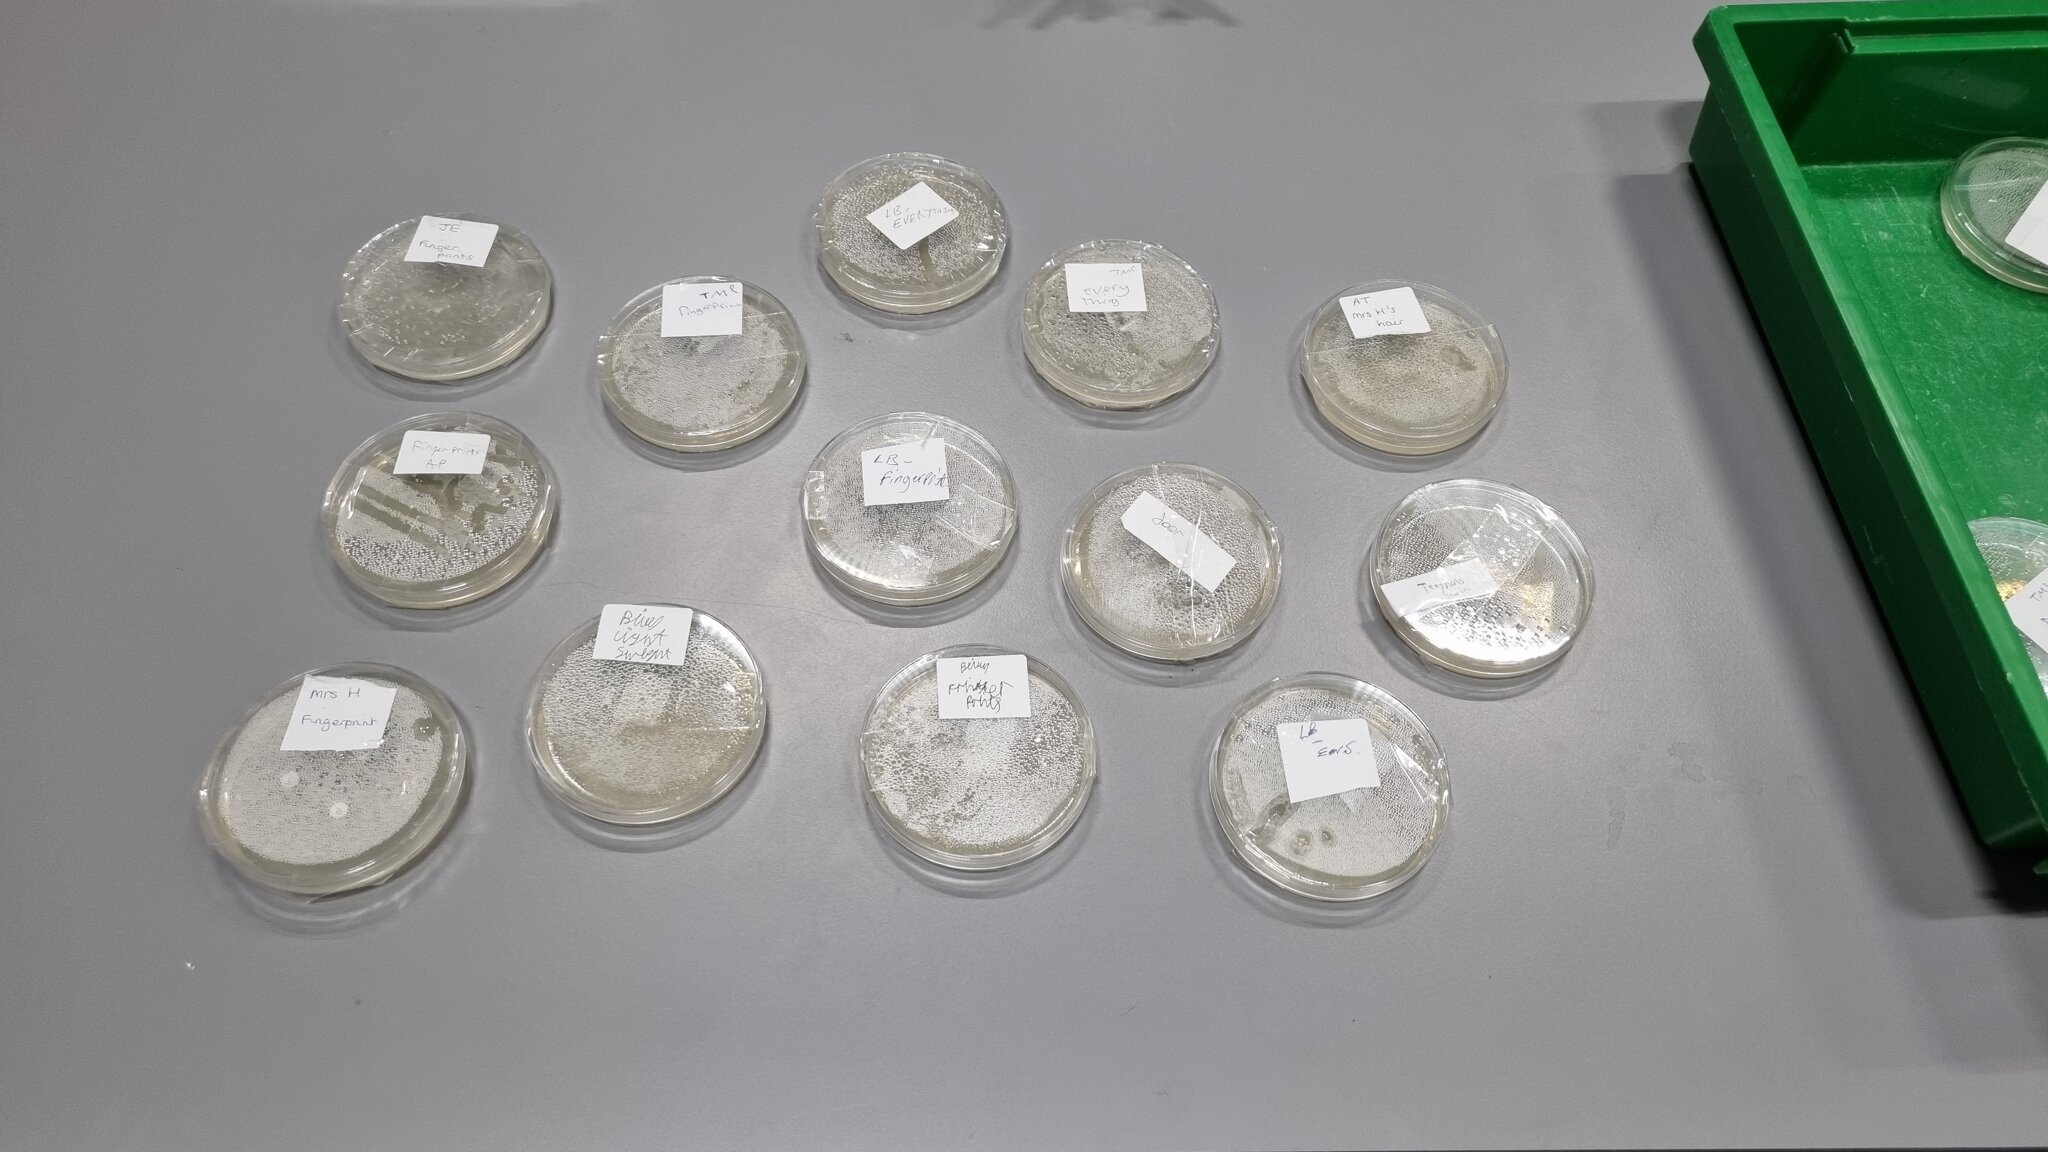
Image of Science Agar Plates

Year 10 have prepared agar plates today with swabs taken from various contact areas around school as part of their Health, Disease and Development of Medicines topic. I wonder what will grow over the weekend?
Year 10 have prepared agar plates today with swabs taken from various contact areas around school as part of their Health, Disease and Development of Medicines topic. I wonder what will grow over the weekend?